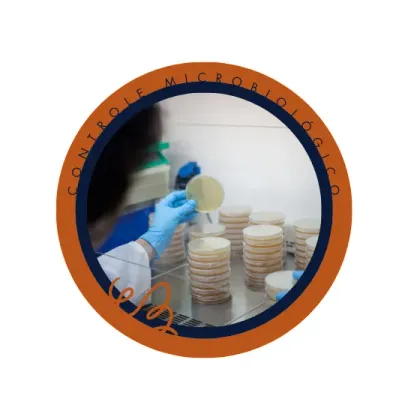

Meire Ota
Sou bióloga de formação e meu amor pela microbiologia começou no ensino médio, durante o curso técnico. Desde o primeiro ano de faculdade até os dias de hoje, a microbiologia está presente na minha vida profissional.
Sempre gostei muito de ensinar e acredito que a educação pode transformar vidas.
Atuando com industrias farmacêuticas desde 2008 vejo a escassez de treinamentos específicos voltados para nossa área e por esse motivo, a Microphar foi desenvolvida para auxiliar novos profissionais, desenvolver profissionais mais capacitados e solucionar problemas do dia-a-dia.